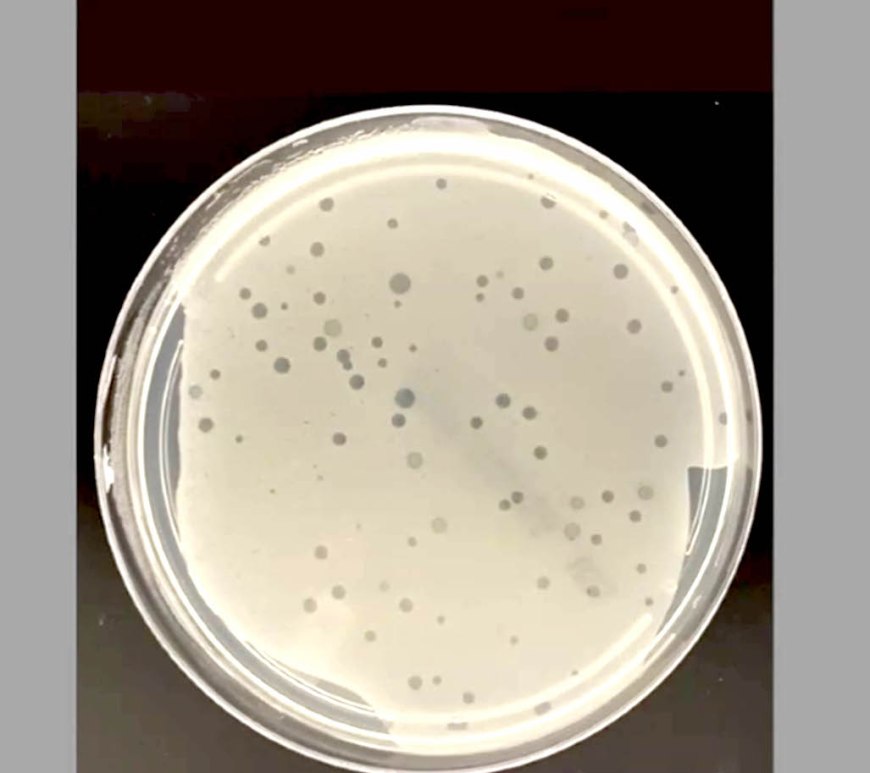

Encabeza Gobernador la segunda Rodada Familiar Papaloapan
Anuncia rehabilitación de la carretera Carlos A. Carrillo-Cosamaloapan Chacaltianguis, Ver., 16 de julio de 2023.- Acompañado de más de 700 personas, este domingo el gobernador Cuitláhuac García Jiménez encabezó la Rodada Familiar Papaloapan II en un recorrido de 18 kilómetros de Carlos A. Carrillo a Chacaltianguis. Durante la convivencia, que contribuye a la promoción turística e impulso de las economías regionales, el mandatario expresó que … Continúa leyendo Encabeza Gobernador la segunda Rodada Familiar Papaloapan